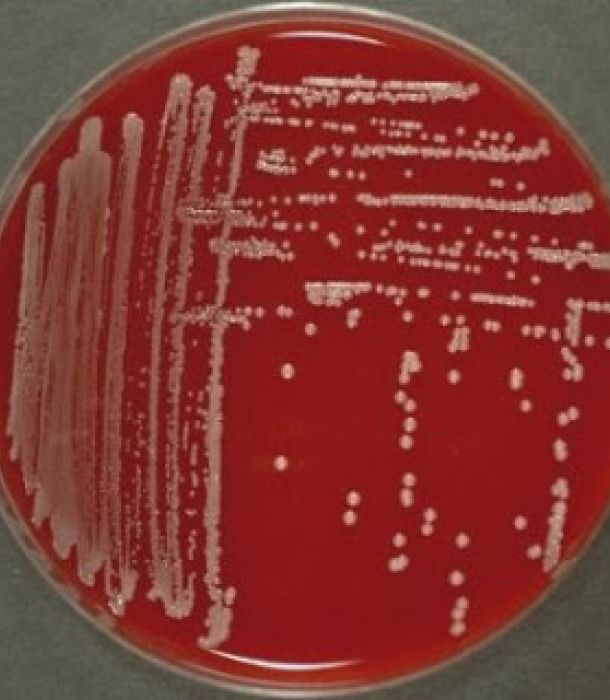

Bioprospección
La bioprospección es el proceso de búsqueda y exploración de organismos vivos en diversos ecosistemas para identificar compuestos bioactivos, genes o microorganismos con potencial aplicación en medicina, agricultura, biotecnología y otras industrias. Este enfoque se centra en descubrir nuevas moléculas útiles para el desarrollo de productos farmacéuticos, agrícolas y energéticos, promoviendo la innovación basada en la biodiversidad.
Bacteriófagos contra Salmonella
Interaction between Cutibacterium acnes, bacteriophages and keratinocytes as a study model of acne phage therapy
Juan Camilo Farfán
Estudiante de doctorado en ciencias biológicas.

Mi proyecto de investigación se enfoca en entender como la fagoterapia puede ser utilizada como alternativa terapéutica para el acné. Esta enfermedad dermatológica se caracteriza por ser de naturaleza inflamatoria y es causada por una diversidad de factores, entre ellos una bacteria llamada Cutibacterium acnes filotipo IA1. Este filotipo está asociado a la generación de respuestas inflamatorias en la piel. Los bacteriófagos (o fagos) pueden eliminar específicamente bacterias, incluso a nivel de cepa. Además, se ha reportado que algunos tienen efectos anti-inflamatorios. En mi proyecto de tesis doctoral encontré que C. acnes IA1 causa citotoxicidad y disminución del crecimiento de queratinocitos, que son células de la piel. Además, induce la producción de un marcador inflamatorio llamado interleuquina 1 beta. Al aplicar fagos a queratinocitos colonizados con C. acnes IA1 se pudo observar que éstos están relacionados con disminución de la citotoxicidad y aumento de la tasa de crecimiento. Además, los fagos pueden reducir el inóculo de C. acnes IA1 en co-cultivo con queratinocitos.
Biosensor basado en fagos para la detección rápida y sensible de Salmonella Enteritidis y Salmonella Typhimurium.
Sebastian Chinchilla Sarmiento
Estudiante de maestría en ciencias biológicas.

Mi proyecto trata de desarrollar un biosensor electroquímico utilizando un bacteriófago modificado genéticamente, específicamente φSan23, para la detección y cuantificación precisa de Salmonella enterica serotipo Enteritidis. Se busca mejorar su capacidad de detección, evaluar la estabilidad y vida útil del biosensor en condiciones de almacenamiento y uso prolongado, además, optimizar las condiciones de ensayo para asegurar una detección sensible ajustando parámetros en la señal electroquímica.
Vtalpets
Daniela Guzmán
Estudiante de pregrado en microbiología

Mi proyecto de grado es Vtalpets, un innovador yogurt griego natural, deslactosado, enriquecido con cinco probióticos, un prebiótico y trozos de fruta deshidrata, diseñado específicamente para perros (Cannis Lupus familiaris). Combinando ciencia, negocios, una pasión general por el bienestar animal, y unas formulaciones basadas en la investigación microbiológica avanzada y necesidades nutricionales de las mascotas; Vtalpets llega a ofrecer un snack funcional, capaz de promover la salud digestiva, apoyando el sistema inmunológico, óseo, articular, sanguíneo, y el bienestar general de los perros, trayendo consigo un gran número de beneficios.
Servicios CIMIC
Juliana Valentía Arias Bonilla
Asistente de investigación

Aproximaciones a la modificación genética de de φSan23
Johan David Fajardo
Estudiante de pregrado

Mi tesis se enfoca en el desarrollo de una estrategia para la modificación genética dirigida del fago φSan23, que infecta a la bacteria Salmonella. Para lograr esto, empleamos una técnica de recombinación in vivo, en la que el genoma del fago φSan23 es modificado mediante la integración de un constructo de ADN exógeno. Como parte del proyecto, intentaré expresar la proteína fluorescente GFP junto con una etiqueta His-tag. El objetivo principal es estandarizar esta técnica, de modo que sirva como base para futuras investigaciones en el laboratorio, permitiendo una modificación genética más precisa y eficiente de fagos dentro del laboratorio.
Trabajos pasados
Evaluación del uso de bacteriófagos para el biocontrol de aislamientos de Klebsiella pneumoniae multidrogoresistente en cuatro materiales de superficies comunes en entornos clínicos
Andrea Katherine Alvarez Osorio
Estudiante de maestría
2023
La alta prevalencia de Klebsiella pneumoniae multirresistente (MDR) en entornos hospitalarios, su detección en diversas superficies clínicas, la resistencia global a los antibióticos y la existencia de cepas resistentes a desinfectantes subrayan la necesidad urgente de nuevas alternativas para su control. Este proyecto investigó el uso de bacteriófagos para reducir la carga bacteriana en materiales comunes en entornos clínicos como acero, tela, PVC y poliestireno. Se evaluó la supervivencia de los aislados de K. pneumoniae en estos materiales, observándose que pueden sobrevivir hasta 24 horas con reducciones de 0.49-1.89 y 1.69-3.88 LOG CFU a 24°C y 37°C, respectivamente. Posteriormente, se aislaron bacteriófagos de aguas residuales hospitalarias, seleccionando tres de ellos en función de su actividad contra el mayor número de aislados. Se llevaron a cabo estudios tanto individuales como combinados para evaluar su actividad antimicrobiana en superficies. Desde la hora 0 post aplicación, con un MOI de 1000, se registraron reducciones de hasta 1 LOG UFC a 24°C y 37°C. El fago 27, que mostró la mayor reducción y un amplio rango de hospedadores, fue elegido para estudios adicionales y secuenciación, que confirmó que es un fago lítico sin genes lisogénicos conocidos. Estos hallazgos respaldan la efectividad de los bacteriófagos como desinfectantes y sugieren su uso complementario en protocolos de saneamiento hospitalario, especialmente durante brotes, para eliminar eficazmente patógenos MDR.
Análisis de microbiota de leche de manatí antillano (Trichechus manatus) y evaluación de bacterias con potencial probiótico
Julliana Valentina Arias Bonilla
Estudiante de pregrado
2021

El objetivo principal de mi investigación es caracterizar la composición microbiana de la leche materna del manatí antillano, utilizando técnicas de secuenciación masiva de ADN (16S) y métodos tradicionales de cultivo microbiológico. Esto con el fin de desarrollar una fórmula sintética para crías de manatíes en cautiverio. Para lograrlo, identifiqué bacterias beneficiosas presentes en la leche materna del manatí y evalué su potencial probiótico mediante diversas pruebas. Esta investigación ofrece una alternativa viable para reemplazar los productos comúnmente utilizados en la cría de manatíes en cautiverio, que suelen ser costosos y no satisfacen plenamente los requerimientos nutricionales necesarios para su desarrollo y supervivencia hasta la vida adulta.
Edificio J - Piso 2 - 3
Teléfono: (+57) 601 3 39 4999 Ext 2767 | 1461
Carrera 1 No.18A - 12
Bogotá, Colombia
